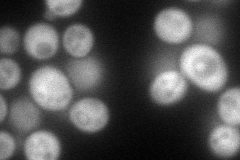
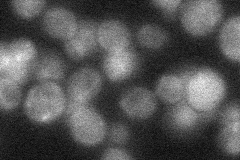
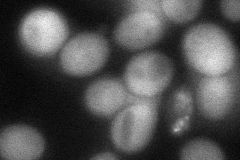
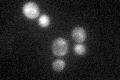

View description
Calmodulin-dependent protein kinase; may play a role in stress response, many CA++/calmodulan dependent phosphorylation substrates demonstrated in vitro, amino acid sequence similar to Cmk2p and mammalian Cam Kinase II
Localization:
Intensity:
Fold change:
Significance:
-
C’ GFP library in SD

cytosol26.56 -
N' NOP1pr-GFP in SD
cytosol110.49 -
N' TEF2pr-mCherry in SD

cytosol142.777 -
N' NATIVEpr-GFP in SD
below threshold29.055 -
N' TEF2pr-VC and Cyto-VN in SD
cytosol62.0277 -
C’ GFP library in SD+DTT

cytosol35.991.35Yes -
C’ GFP library in SD+H2O2

cytosol35.741.34Yes -
C’ GFP library in Starvation Media
cytosol42.061.58No -
C’ GFP library on the background of Pup2-DaMP

cytosol -
C’ GFP library on the background of CCT mutant

cytosol27.82771.04723No
